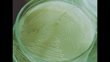
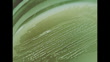

Re-enactment of Alexander's Fleming's experiments with streptococcus
Re-enactment of Alexander's Fleming's experiments with streptococcus bacteria. From Antibiotics: The Search for Invisible Friends. A propaganda film on Soviet advancements in antibiotics. 17 of 58.

DETAILS
Restrictions:
Contact your local office for all commercial or promotional uses.ON HOLD. PLEASE DO NOT LICENSE.
Credit:
Editorial #:
2256598098
Collection:
British Film Institute
Date created:
January 01, 1963
Upload date:
License type:
Rights-ready
Release info:
Not released.ÌýMore information
Clip length:
00:00:18:16
Location:
Soviet Union
Mastered to:
QuickTime 10-bit ProRes 422 (HQ) HD 1920x1080 24p
Source:
British Film Institute
Object name:
n_508357_17
- 1960-1969 Videos,
- Antibiotic Videos,
- Archival Videos,
- Bacterium Videos,
- Biology Videos,
- Color Image Videos,
- Discovery Videos,
- Film - Moving Image Videos,
- Former Soviet Union Videos,
- HD Format Videos,
- Healthcare And Medicine Videos,
- Historical Reenactment Videos,
- Horizontal Videos,
- Laboratory Videos,
- Laboratory Equipment Videos,
- London - England Videos,
- Medicine Videos,
- Microbiology Videos,
- Petri Dish Videos,
- Raw Footage Videos,
- Real Time Video Videos,
- Reenactment Videos,
- Research Videos,
- Science and Technology Videos,
- Scientific Experiment Videos,
- Streptococcus Videos,
- Video with Sound Videos,